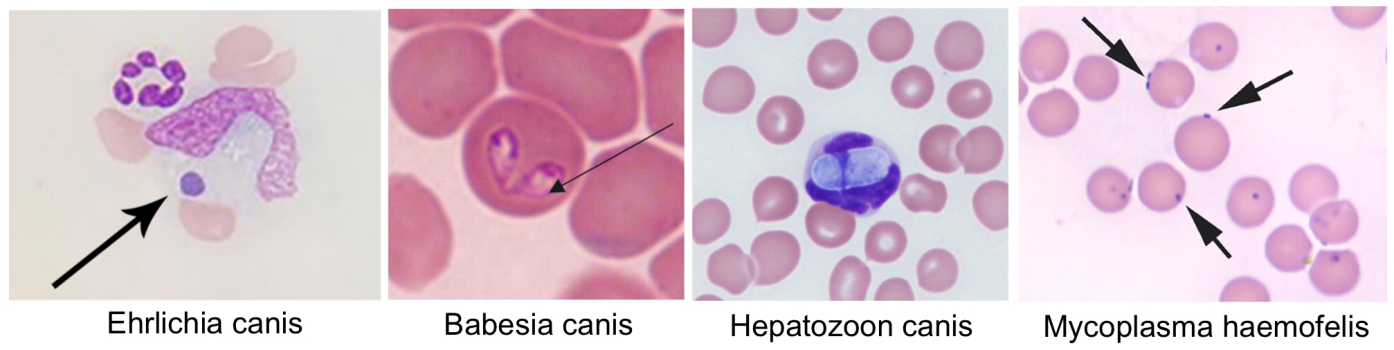

129735 จำนวนผู้เข้าชม |
ผ่านไปไม่นาน ฤดูฝนก็กลับมาอีกแล้ว ช่วงนี้เป็นช่วงที่เจ้าของหลายๆท่านอาจสังเกตเห็นเห็บได้มากกว่าปกติ เนื่องจากอุณภูมิและความชื้นของหน้าฝนเหมาะแก่การเจริญเติบโตและแพร่กระจายของเห็บ ถึงแม้ว่าน้องหมาน้องแมวจะมีการใช้ยาที่ช่วยป้องกันเห็บหมัดแต่ก็ยังไม่สามารถนิ่งนอนใจได้ เนื่องจากเห็บจะต้องกัดสัตว์เลี้ยงก่อนจึงจะได้รับยาเข้าไปในร่างกาย ซึ่งกว่าจะถึงตอนนั้น เชื้อในตัวของเห็บก็ได้ส่งเข้าไปในตัวสุนัขเสียแล้ว

โรคพยาธิเม็ดเลือดที่เราเรียกรวมๆกัน จริงๆแล้วเป็นโรคที่เกิดได้จากเชื้อหลายชนิด โดยเราจะพูดถึงเชื้อที่ก่อโรคในสุนัขกันก่อนเชื้อตัวแรกคือ Ehrlichia spp. ที่พบได้บ่อยมากๆในระเทศไทย หากโดนเห็บที่มีเชื้อกัดหรือได้รับเลือดที่มีเชื้อเช่น การถ่ายเลือด เชื้อตัวนี้จะเข้าไปแอบอยู่ในเม็ดเลือดขาว ตัวที่สองที่พบได้บ่อยเช่นกันคือ Anaplasma spp. แตกต่างที่เจ้าตัวนี้จะเข้าไปแอบอยู่ในเกล็ดเลือด พยาธิเม็ดเลือดทั้งสองตัวจะทำให้สัตว์ป่วยมีอาการเหมือนกัน คือ
1. ระยะแรกหรือ acute stage จะพบว่ามีการป่วยเหมือนโรคทั่วๆไปซึม เบื่ออาหาร มีไข้ หรือหากรุนแรงอาจพบมีจุดเลือดออกได้ ระยะนี้จะเป็นช่วง 1-4 สัปดาห์แรกของการติดเชื้อ
2. ระยะต่อมาคือช่วง 40-120 วันหลังจากติดเชื้อ เป็นระยะ subclinical stage ไม่แสดงอาการ แต่หากตรวจเลือดสามารถเจอปริมาณเกล็ดเลือดและเม็ดเลือดแดงต่ำได้
3. ระยะเรื้อรังหรือ chronic stage คือติดเชื้อมาเป็นเวลานานแล้ว มักพบว่าสุนัขมีสีเยื่อเมือกซีด มีจุดเลือดออก สามารถพบเลือดกำเดาไหลได้ หากเกิดสภาวะแทรกซ้อนอาจพบว่ามีภาวะปอดบวม ไตวายเฉียบพลัน ข้ออักเสบ เยื่อหุ้มสมองอักเสบ ม่านตาอักเสบ เป็นต้น
พยาธิเม็ดเลือดตัวต่อมาที่อยากจะกล่าวถึงคือ เชื้อ Babesia spp. ที่เข้าไปอยู่ในเม็ดเลือดแดงของน้องหมาทำให้เม็ดเลือดแดงเกิดความผิดปกติไป ร่างกายจึงเข้าใจว่าเม็ดเลือดแดงเป็นสิ่งแปลกปลอมต้องกำจัดออก จึงสร้างภูมิคุ้มกันมาทำลายเม็ดเลือดแดง เราเรียกภาวะนี้ว่า Immune Mediated Hemolytic Anemia (IMHA) หรือภาวะโลหิตจางเนื่องจากภูมิคุ้มกันทำลายเม็ดเลือดแดงตัวเอง ทำให้น้องหมามีภาวะโลหิตจางและอาจพบภาวะ “ดีซ่าน” เยื่อเมือกและเยื่อบุตาขาวมีสีเหลืองได้

แล้วถ้าเห็บไม่ได้กัด แต่น้องหมาบังเอิญกินเห็บเข้าไปล่ะ จะส่งผลอะไรกับตัวน้องหมามั้ย คำตอบก็คือ มีพยาธิเม็ดเลือดตัวที่สี่ ชื่อ Hepatozoon spp. ที่สามารถเกิดการติดเชื้อได้จากการที่น้องหมากินเห็บที่มีเชื้อเข้าไป ซึ่งในประเทศไทยเกิดจากเชื้อ สามารถพบได้ในสุนัขทุกเพศทุกวัย อาการไม่จำเพาะเจาะจงเช่น ซึม เบื่ออาหาร มีภาวะโลหิตจาง
ถึงแม้ว่าโรคที่ได้กล่าวมาข้างต้นจะเป็นโรคที่พบได้ในสุนัข แต่เหล่าทาสแมวก็ยังนิ่งนอนใจไปไม่ได้ เพราะจริงๆแล้วน้องแมวก็สามารถเป็นโรคพยาธิเม็ดเลือดได้เช่นกัน นั่นคือโรคที่ชื่อว่า Hemotropic Mycoplasmosis เป็นโรคพยาธิเม็ดเลือดที่สามารถติดได้ทั้งในสุนัขและแมว เกิดจากการติดเชื้อผ่านแมลงดูดเลือด เห็บ รวมถึง ”หมัด” ด้วย นอกจากนี้ยังสามารถติดเชื้อผ่านการคลอดจากแม่สู่ลูกได้อีกด้วย ถือว่าเป็นโรคที่ไม่ธรรมดาเลยทีเดียว อาการของโรคนี้ก็คล้ายคลึงกับการติดพยาธิเม็ดเลือดชนิดอื่นๆคือ ซึม เบื่ออาหาร มีภาวะโลหิตจาง ตัวเหลือง เป็นต้น

วิธีการตรวจโรคพยาธิเม็ดเลือด
1. Test kit การตรวจวิธีนี้สามารถตรวจโรคได้ 4 โรค ซึ่งโรคพยาธิเม็ดเลือดที่ตรววจได้คือEhrlichiosis และ Anaplasmosis ส่วนอีก 2 โรคคือ Lyme disease และ โรคพยาธิหนอนหัวใจ ข้อควรระวังคือหากสุนัขเคยเป็นพยาธิเม็ดเลือดมาก่อนและรักษาหายแล้ว ก็จะยังให้ผลบวกอยู่ แม้ในขณะนั้นไม่ได้เป็นโรคจริงๆ
2. การตรวจภายใต้กล้องจุลทรรศ์ เป็นการตรวจเพื่อหาเชื้อที่เกาะอยู่ในเม็ดเลือดชนิดต่างๆ หากตรวจพบก็จะสามารถยืนยันได้ว่าเป็นโรคนี้จริง แต่หากไม่พบเชื้อจะไม่สามารถแปลผลว่าไม่เป็นโรคนั้นๆได้ เนื่องจากเป็นการนำตัวอย่างเลือดมาใช้ไม่กี่หยดเท่านั้น จึงไม่สามารถสรุปผลโดยรวมเลือดทั้งหมดในร่างกายไม่มีเชื้ออยู่จริงๆ
3. PCR การตรวจวิธีนี้สามารถตรวจได้ทุกโรคที่กล่าวมาและเป็นวิธีที่ให้ผลได้แม่นยำที่สุด แต่ก็จะใช้ระยะเวลานานที่สุดเช่นกันค่ะ
การรักษาโรคพยาธิเม็ดเลือด
การรักษาโรคพยาธิเม็ดเลือดสามารถรักษาได้ด้วยการกินยาฆ่าเชื้อและการฉีดยาซึ่งจะขึ้นกับชนิดของเชื้อก่อโรค ซึ่งมักต้องรักษากันยาวนานร่วมเดือน ในกรณีที่มีภาวะโลหิตจางมีการให้กินยาบำรุงเลือดร่วมด้วย แต่หากภาวะโลหิตจางมีความรุงแรงสัตว์ป่วยอาจต้องได้รับการถ่ายเลือด และแน่นอนว่าการใช้ยาป้องกันเห็บหมัดก็ยังเป็นสิ่งที่จำเป็น ถึงแม้จะไม่สามารถกันการเกิดโรคพยาธิเม็ดเลือดได้ทั้งหมด แต่ช่วยลดความเสี่ยงลงไปได้มากค่ะ
..........................................................
บทความโดย สพ.ญ. เภตรา หลักทอง
Photo credit: mspca.org, thesprucepets.com, tvmdl.tamu.edu, researchgate, vetstream, vetpal และ msdvetmanual